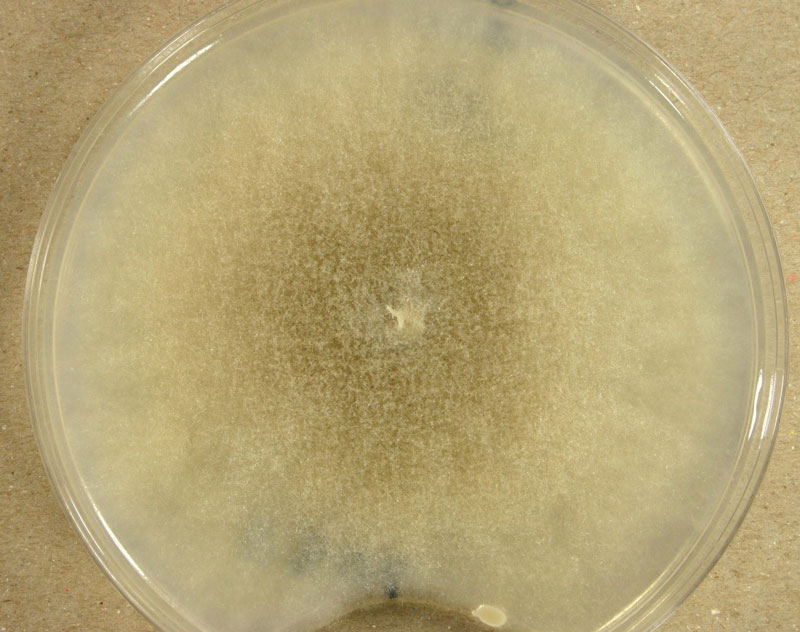

Bull. 1791
What is Mucor racemosus?
Mucor racemosus is a mold belonging to the order Mucorales and phylum Zygomycota [1, 2]. This species is also known as Chlamydomucor racemosus, Mucor dimorphosporus, Mucor christianesis, and Mucor varians [2]. It commonly inhabits soil, decaying plant material, and buildings. However, its presence is reported in human and animal tissue as well.
Like many other Mucorales species, M. racemosus is capable of switching from filamentous to a yeast-like form. This morphogenetic adaptation called dimorphism enables this mold to colonize a host quickly and is an essential factor of its pathogenicity.

Culture and biology of M. racemosus
M. racemosus is one of the first discovered and isolated soil fungi. It multiplies under aerobic conditions, forming a thick, smoke—grey mycelium up to 40mm high when grown on malt extract agar. The mycelium consists of both aerial and substrate hyphae, which gradually darken due to the accumulation of sporangia with dark sporangiospores.
Sporangia are formed by apical swelling of long, branched sporangiophores. Columellae are oval or ovoid, brownish. Sporangiospores are oval and ellipsoidal, greyish and their function is asexual reproduction [2, 3].
M. racemosus can also be reproduced sexually by zygospores. A single zygospore is enclosed in a zygosporangium formed by the fusion of compatible mating types of hyphae.
In the same medium, but under strictly anaerobic conditions, conversion to yeast form is stimulated as sporangiospores germinate as budding yeast cells.

Where is Mucor racemosus found?
Along with M. hiemalis, M. racemosus is considered the most typical species of the genus Mucor due to its worldwide distribution. The presence of M. racemosus has been reported in Alaska, Greenland, Europe, Africa, Israel, Iraq, India, Indonesia, Brazil, and Chile [2].
Records suggest that it appears equally in a great variety of soils and vegetation types, including forests, wet and dry grasslands, steppe, dunes, salt marshes, and saline soils, caves, mines, sewage sludges, as well as in running freshwater [2].
According to data obtained from soil studies, M. racemosus preferentially colonizes the uppermost soil layers with pH values between 4.4-8. Its growth is strongly enhanced by applying NPK fertilizers and farmyard manure [2].
Being one of the most common inhabitants of soil mycoflora, M. racemosus has also been found on dung, nests, and feathers of free-living birds, in honeycombs, in the air, house dust as well as in the seeds, fruits, and roots of different plants [2, 3]. Like other Zygomicetes, it is widely present in basements, bathrooms, kitchens, laundry rooms, and saunas, and pools [8].
What are causes and symptoms of Mucor racemosus infection?
Despite its inability to grow at temperatures higher than 32°C, M. racemosus is considered an infection agent and other Mucor species [4]. Causing no evident issues in healthy people, it is a significant opportunistic pathogen of individuals with compromised immune systems such as children, elderly, and patients chronically diseased from diabetes, metabolic acidosis, AIDS, Ebola, COVID, malignant hematological disorders or treated with corticosteroid drugs due to organ transplantation [5, 6].
The underlying causes influence the clinical manifestation of mucormycosis. For example, people with diabetes usually develop a rhinocerebral form, whereas patients with malignant hematological disease or lymphoma usually suffer from a pulmonary form of mucormycosis. Both forms of the disease are acquired through the inhalation of spores. Ingestion of contaminated food leads to gastrointestinal mucormycosis occurring in infants and transplant recipients. At the same time, direct skin contact causes cutaneous mucormycosis, particularly in neonates and patients with skin burns and trauma [6].
The clinical manifestation of all mucormycosis forms is the rapid necrosis of tissues, resulting from invasion of blood vessels and thrombosis. In most cases, the infection is progressive and fatal [6].
What are symptoms of Mucor racemosus infection?
- Rhinocerebral mucormycosis begins with sinusitis followed by fever, facial pain, headache, drainage, and soft tissue swelling. Sometimes infection extends into the mouth, producing painful, necrotic ulceration of the hard palate or the eyes, leading to blindness. It can be spread from sinuses to the nervous system, and bloody nasal discharge is one of the first signs of that infection stage [6].
- Pulmonary mucormycosis symptoms include fever, dyspnea, and cough. If untreated, the infection disseminates throughout blood vessels, and patients usually die before respiratory failure occurs [6].
- In its primary infection stage, cutaneous mucormycosis produces an acute inflammatory response with pus, swelling, and necrosis. In the same cases, aerial mycelia can be noticed on the lesion surface. Mycelia spreads from cutaneous and subcutaneous tissue to muscle, fat, and bone tissues, causing necrotizing fascitis with a high mortality rate. The secondary stage of infection is vascular, leading to disseminated infection of the deep organs [6].
- Gastrointestinal Mucormycosis is rare but acute and rapidly fatal. Symptoms include nonspecific abdominal pain, nausea, and vomiting. It is usually diagnosed upon death by biopsy [6].
- Various forms without previous symptoms are also reported since agents of Mucorales, disseminated through blood vessels, may cause infection in virtually any organ, including the brain, heart, kidneys, and even bones [6].

Mucor racemosus allergy
While described forms of mucormycosis are present exclusively in immunocompromised individuals, allergies caused by Mucor species have been reported in immunologically healthy people worldwide [7]. Symptoms include sinusitis, rhinitis, and alveolitis in healthy people, while asthmatic patients are at higher risk due to anaphylactic reaction [8, 9]. Tests based on the production of IgE antibodies specific to Mucor racemosus are widely used in diagnostic sensitivity to Mucor species. They are available for medical and laboratory use in allergen assay [9, 10].
How to treat Mucor racemosus?
Due to its progressiveness, infections caused by Mucor racemosus are often inadequate to control by antifungal therapy alone. Surgical excision of infected tissue is mandatory in many cases. Other essential factors include early diagnosis and controlling predisposing problems [6]. Because Mucor racemosus is resistant to a wide range of fungistatic drugs [1], preventive measurements must be taken to avoid inhaling its spores or getting in touch with its mycelia. Since M. racemosus is ubiquitous and can be found in any modern building, thorough eradication performed by equipped professionals is recommended.

Did you know?
Only 11% of tested bedrooms in Canada didn’t have any mold type present?! Find out more exciting mold stats and facts on our mold statistics page.
References
- Szanislo P. J. (1985). Fungal Dimorphism With Emphasis on Fungi Pathogenetic for Humans. Texas Department of Health and University of Texas at Austin. Austin, Texas. pp 343-356.
- Domisch, K. H.; Gams, W. and Anderson, T. H. (1980). Compendium of Soil Fungi. Academic Press, London. pp 477-480.
- Abdel-Hafez, S. I. and Shoreit, A. A. (1985). Mycotoxins producing fungi and mycoflora of air-dust from Taif. Mycopathologia 92 (2): 65-71
- Ellis D (2019). Mucor. Retrieved from mycology.adelaide.edu.au.
- 5. Dyer, O. (2021). Covid-19: India sees record deaths as “black fungus” spreads fear. British Medical Journal (Online); London Vol. 373. doi: doi.org
- Dismukes, W.E.; Pappas, P.G. and Sobel, J.D. (2003). Clinical Mycology. Oxford University Press, Oxford. pp 241-251.
- Weber, R.W. (2015). Allergen of the month – Mucor. Annals of Allergy, Asthma, and Immunology. 115 (2): A15
- Zukiewicz-Sobczak, W. A: (2013). The Role of Fungi in allergic diseases. Postepy Dermatol Alergol. 30(1): 42–45.
- TEST ID: MUC. Mucor IgE Serum test, Mayo Clinic
- “Mucor Racemosus IgE”. Viracor.IBT Laboratories.

Get Special Gift: Industry-Standard Mold Removal Guidelines
Download the industry-standard guidelines that Mold Busters use in their own mold removal services, including news, tips and special offers:

Written by:
Jelena Somborski
Mycologist
Mold Busters
Edited by:
Dusan Sadikovic
Mycologist – MSc, PhD
Mold Busters
